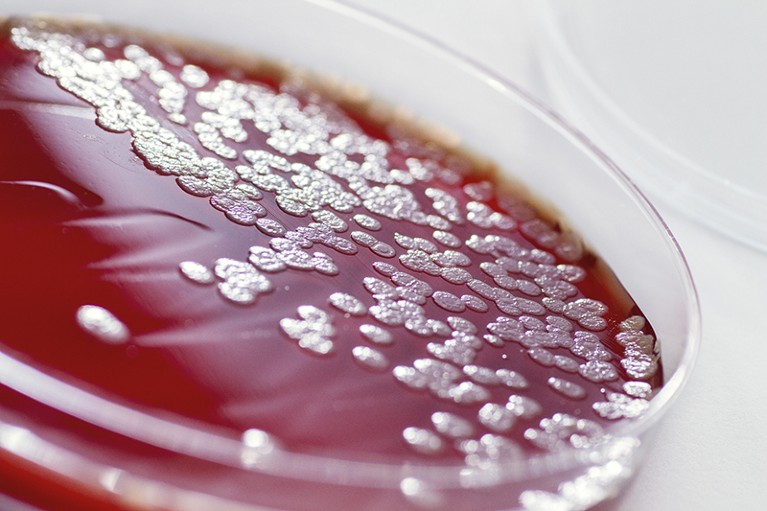
A Petri dish with bacteria growing on it

Credit: Russell Cobb
When Neil Sweezey started working as a clinician in the 1980s, he began to spot a strange pattern in his patients with cystic fibrosis. Girls with the genetic disease seemed to be coming into hospital with lung damage or infection more often than boys with the same condition. That trend stands in opposition to the more general pattern of women edging out men on health metrics. “The fairer sex is also the tougher sex,” explains the pulmonologist at the Hospital for Sick Children in Toronto, Canada — pointing out that on average, women live for six to eight years longer than men. “Whereas if you look at the cystic fibrosis population, it is flipped the other way. The girls are dying off faster.”
A comprehensive analysis in 1997 of more than 21,000 people with cystic fibrosis in the United States showed a median life expectancy of 25.3 years for women and 28.4 for men1. The bacteria associated with lung decline and early death were also found to be present in women earlier than in men. (Nature recognizes that sex and gender are not the same, and are neither fixed nor binary.)
Some scientists argued that the reason for the difference was simply that men were better at adhering to their treatment plans than women, Sweezey says. But others were confident that a biological mechanism was to blame. Some anticipated it might be a difficult riddle to solve, with an answer spanning multiple disciplines.
The gender gap mystery
A decade and a half after that US analysis, a medication called ivacaftor (marketed as Kalydeco by Vertex Pharmaceuticals of Boston, Massachusetts) became available. It corrects certain mutations in the cystic fibrosis transmembrane conductance regulator (CFTR) protein that are at the root of the disease. Pulmonologist Raksha Jain at the University of Texas Southwestern Medical Center in Dallas wondered whether the topic of sex differences in cystic fibrosis was still relevant — perhaps this drug had plugged the gap. Her findings2 showed that was not the case. “We controlled for a lot of different variables that are known to impact how somebody does with cystic fibrosis,” she explains. “Despite all that, women had a fairly large difference in their survival relative to men — they were dying three to four years earlier.”
Part of Nature Outlook: Cystic fibrosis
So what was going on? The first clue, says physiologist Brian Harvey at the Royal College of Surgeons in Dublin, was that lung exacerbations (worsening of respiratory symptoms) occurred in women with the disease at around the time they reached puberty. Given the timing, he surmised that sex hormones must be playing a part in this discrepancy. So Harvey and his colleagues set out to map the effects of the menstrual cycle on cystic fibrosis progression. “We found that in the mid-cycle when oestrogen levels were highest, lung exacerbations were also at their highest,” he says.
The next step was to work out how endogenous oestrogen could be contributing to a worsening of the condition. One hypothesis involved the hormone’s effect on ion transport in the lungs. In cystic fibrosis, this is already disrupted. People with the disease lack a working version of CFTR, the protein responsible for regulating chloride transport. This deficit leads to the dehydration of a thin layer of fluid in the lungs called the airway surface liquid and results in a build-up of mucus. But experiments found that in women, CFTR might not be the only problem.
In lung samples from women with cystic fibrosis, oestrogen was found to modulate an epithelial sodium channel, leading to further reduction of the airway surface liquid, which in turn makes the mucus even harder to clear3. “The more the ion transport is compromised, the less hydrated the lung lining becomes,” says Harvey. “Then the more mucus gets stuck. And bacteria colonize the lung and become lodged long-term in the airways.”
But oestrogen’s effect was not limited to mucosal fluid dynamics in the lungs. Researchers also found a microbiological difference between men and women. In cystic fibrosis, arguably the most important bacterium is Pseudomonas aeruginosa, which contributes to many of the most serious infections in people with the disease. This microorganism was causing problems much earlier in women than in men. Clinician Sanjay Chotirmall at the Lee Kong Chian School of Medicine of Nanyang Technological University in Singapore wondered whether oestrogen could be directly helping the aggressive bacterium. Sure enough, while working on his PhD in Harvey’s laboratory, Chotirmall found that in an oestrogen-rich environment, P. aeruginosa forms biofilms that are harder for the immune system to eradicate.
A Pseudomonas aeruginosa bacterial culture.Credit: Daniela Beckmann/SPL
And intriguingly, the Dublin group showed that women who were taking oral contraception needed fewer courses of antibiotics to keep cystic fibrosis-related infections in check than did women not on hormonal birth control4. “When a woman takes the pill, it tricks the body into thinking there’s oestrogen hanging around until her own endogenous oestrogen gets suppressed,” Chotirmall says. If women who take the pill get fewer infections, perhaps natural oestrogen exacerbates cystic fibrosis. However, researchers at Imperial College London found no differences in clinical outcomes in cystic fibrosis between women who were taking oral contraceptives and those who weren’t5.
Hormonal differences
In April 2020, Harvey and a colleague6 found that oestrogen exacerbates P. aeruginosa infections by allowing the bacterium to better penetrate the lungs in cystic fibrosis. Unsurprisingly, the oestrogen blocker tamoxifen was shown to inhibit this action. “It’s a double whammy,” Harvey sums up. “Oestrogen is not only affecting the airway epithelium dynamics, but also affecting the virulence of the bacteria.”
In Sweezey’s lab, experiments have pointed to yet another possible hormonal explanation for the gender gap in cystic fibrosis outcomes. Oestrogen might affect the immune system, prompting white blood cells to recruit excessive amounts of inflammatory cells called cytokines to the infected tissue. Inflammation is a big problem in cystic fibrosis, contributing to airway damage and life-threatening infections. Sweezey’s results indicated that inflammation-related damage is more pronounced in women with the disease than in men.
Although this research points to oestrogen-blocking drugs as having a possible value for treating cystic fibrosis in women, Jain thinks more development is needed before such treatment could produce benefits that outweigh the downsides. Oestrogen blockers cause side effects such as hot flushes, mood problems and insomnia, and could cause young women to enter premature menopause, which is linked to an increased risk of heart disease and bone disorders. Although menopause could be reversed if treatment was stopped, patients would probably have to take hormone inhibitors continuously. “When I’ve applied for grants,” Jain says, “people have said they’re not going to take away a woman’s oestrogen. If it’s not something you can change, should you really spend many years studying this?” One potential solution, she says, could be the development of more-targeted, inhaled oestrogen inhibitors that act only on the lungs.
The XX factor
Although the hormonal hypothesis would be a tidy explanation for the gender difference in cystic fibrosis, things might not be so neat. Differences between the sexes have also been observed in children with cystic fibrosis long before puberty, suggesting that oestrogen isn’t the only piece of the puzzle. Always in the back of researchers’ minds, Sweezey says, is the question: might it be chromosomal?
Women typically have two X chromosomes, whereas men typically have an X and a Y chromosome. Although the X chromosome contains vital genes, it would be damaging to have a double dose of them. To correct this, a process called X-chromosome inactivation silences one of the X chromosomes when they occur in a pair. But this mechanism isn’t as thorough as might be expected; some of the muted genes leak through. “There are a lot of immunity genes encoded on the X chromosome,” says microbiologist Catherine Greene at the Royal College of Surgeons in Dublin. Higher levels of these immunity genes are likely to make women more robust against certain diseases, but more susceptible to others. One theory suggests that these genes promote an inflammatory response that helps to clear acute infections, but that is less useful in chronic conditions such as cystic fibrosis.
Greene decided to find out whether microRNAs (small, non-coding nucleic acids that inhibit certain genes) from the X chromosome were different between boys and girls with cystic fibrosis. Initial experiments found no such differences. But then Greene’s group looked at all microRNAs (not just the ones on the X chromosome) in blood samples from children under six with cystic fibrosis7. This time, they found that levels of a microRNA called miR885-5P were higher in girls than in boys. This molecule seems to inhibit the action of RAC1, a protein that regulates CFTR. The finding could be particularly relevant given that the research spotlight is currently on drugs that target CFTR.
The drugs might work
A few months before Greene’s study was published, the US Food and Drug Administration approved a therapy for cystic fibrosis that seems to help clear patients’ airways of mucus at a higher rate than any other medication. Marketed as Trikafta by Vertex Pharmaceuticals, the treatment is a twice-daily combination of three CFTR modulators: elexacaftor, ivacaftor and tezacaftor. Higher levels of miR885-5P in women would correspond to lower levels of RAC1, which might influence how well women respond to Trikafta, because RAC1 regulates the protein that Trikafta targets. “If there’s more RAC1 present in a cell, you’re likely to get a better response. This might suggest very, very vaguely that females could have a poorer response to this treatment,” says Greene. She cautions, however, that more research, with much larger sample sizes, is needed to confirm this observation.
As more people with cystic fibrosis get access to Trikafta, better data will emerge on the population groups that are most likely to benefit from it. If women don’t seem to gain as much from the triple combination, perhaps an adjunct therapy (such as a contraceptive pill, hormone blocker or microRNA inhibitor) might improve their response. “It’s wonderful that we have this triple-drug combination, but the job’s not done,” says Sweezey. “We need to keep on looking for other areas which contribute in a significant way to cystic fibrosis health. This gender business is one of those ways.”


 Cystic fibrosis drugs target the malformed proteins at the root of the disease
Cystic fibrosis drugs target the malformed proteins at the root of the disease
 A simple test could extend cystic-fibrosis treatments to those left behind
A simple test could extend cystic-fibrosis treatments to those left behind
 In utero intervention to stem the damage of cystic fibrosis
In utero intervention to stem the damage of cystic fibrosis
 Bacteria-eating viruses could provide a route to stability in cystic fibrosis
Bacteria-eating viruses could provide a route to stability in cystic fibrosis
 Gene therapy could offer an inclusive cure for cystic fibrosis
Gene therapy could offer an inclusive cure for cystic fibrosis
 The coronavirus pandemic has forced rapid changes in care protocols for cystic fibrosis
The coronavirus pandemic has forced rapid changes in care protocols for cystic fibrosis
 Living, breathing proof
Living, breathing proof
 How much protein function needs to be restored in cystic fibrosis?
How much protein function needs to be restored in cystic fibrosis?
 Research round-up: Cystic fibrosis
Research round-up: Cystic fibrosis







